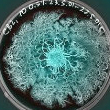

level 11

level 12
继续!图图图!
2015年07月22日 14点07分
2

level 11
只有一个
![[哈哈]](/static/emoticons/u54c8u54c8.png)

level 10
只见花,不见球。漂亮
2015年07月22日 14点07分
4

level 13

level 11
花箭高20㎝花大10㎝
2015年07月22日 14点07分
6

level 11

level 11

level 15

level 13
漂亮!
2015年07月23日 01点07分
10

level 13
2015年07月23日 01点07分
11

可是从来都没留下过!还是留下层主宝贝的身影吧!
2015年07月23日 01点07分

level 11
2015年07月23日 01点07分
12

谁家小宝真可爱
![[真棒]](/static/emoticons/u771fu68d2.png)

你家娃很配合
2015年07月28日 01点07分
应该是沟宝吧?很漂亮的,小子更可爱
2015年07月28日 04点07分

level 7
不错的
2015年07月23日 02点07分
13

level 11
今晚继续更新
2015年07月23日 02点07分
14

level 11
2015年07月23日 03点07分
15

回复 昨夜星塵昨夜風 :是的
2015年07月23日 11点07分

level 11
白色短毛丸三炮齐发
2015年07月23日 11点07分
16

level 11
七点五十五分拍,白色短毛丸和粉色短毛丸



回复
1971����
:上图不是吗?开过了啊!
2015年07月28日 01点07分

level 11
赶上直播
了
2015年07月23日 12点07分
18

level 11

level 7